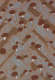

Fujii Tatsukichi
Sosaku senshoku zuanshu
Maker
Fujii Tatsukichi (Japanese, 1881-1964)
Bungado (Japanese), publisher
Title
Sosaku senshoku zuanshu
Year
1933
Materials/Techniques
-
Techniques
Materials
ink, mica (white pigment), colorSupports
Dimensions
-
38.4 x 28.3 cm (15 1/8 x 11 1/8 inches) each sheet
Credit / Object Number
-
Credit
Elizabeth T. and Dorothy N. Casey Fund
Object Number
2007.52 Type
Image use
The images on this website can enable discovery and collaboration and support new scholarship, and we encourage their use.
This object is in copyright
Tombstone
Fujii Tatsukichi (Japanese, 1881-1964)
Bungado (Japanese), publisher
Bungado (Japanese), publisher
Sosaku senshoku zuanshu, 1933
Unbound, woodblock printed book with shibori cover and 50 designs pasted on folded paper.
38.4 x 28.3 cm (15 1/8 x 11 1/8 inches) each sheet
Elizabeth T. and Dorothy N. Casey Fund 2007.52
To request new photography, please send an email to imagerequest@risd.edu and include your name and the object's accession number.
Feedback
We view our online collection as a living documents, and our records are frequently revised and enhanced. If you have additional information or have spotted an error, please send feedback to curatorial@risd.edu.